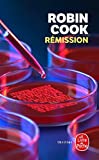

Rémission de Robin Cook
(Cure)
Catégorie(s) : Littérature => Policiers et thrillers

Visites : 3 574
Efficace et divertissant
Voici, une fois de plus, un excellent thriller médical écrit par un auteur qui maîtrise parfaitement ce domaine, étant lui-même chirurgien, désormais à la retraite.
Je sais à l'avance qu'avec Robin Cook je vais passer un bon moment de lecture.
Le scénario est solide, le style tout à fait abordable et à la portée de tous, y compris ceux qui sont totalement étrangers au milieu de la santé.
De plus, retrouver le duo Montgomery-Stapleton ajoute encore un peu plus de plaisir tant ils sont simples et attachants.
Efficace et divertissant, ce thriller atteint pleinement son objectif.
Seul le choix du titre m'échappe quelque peu, car je ne saisis pas franchement le rapport avec l'histoire.
Les éditions
-
Rémission [Texte imprimé], roman Robin Cook traduit de l'anglais (États-Unis) par Pierre Reignier
de Cook, Robin Reignier, Pierre (Traducteur)
le Livre de poche / Le Livre de poche
ISBN : 9782253175766 ; 8,90 € ; 05/06/2013 ; 600 p. Poche
Les livres liés
Pas de série ou de livres liés. Enregistrez-vous pour créer ou modifier une série
Forums: Rémission
Il n'y a pas encore de discussion autour de "Rémission".

haut de page
haut de page
